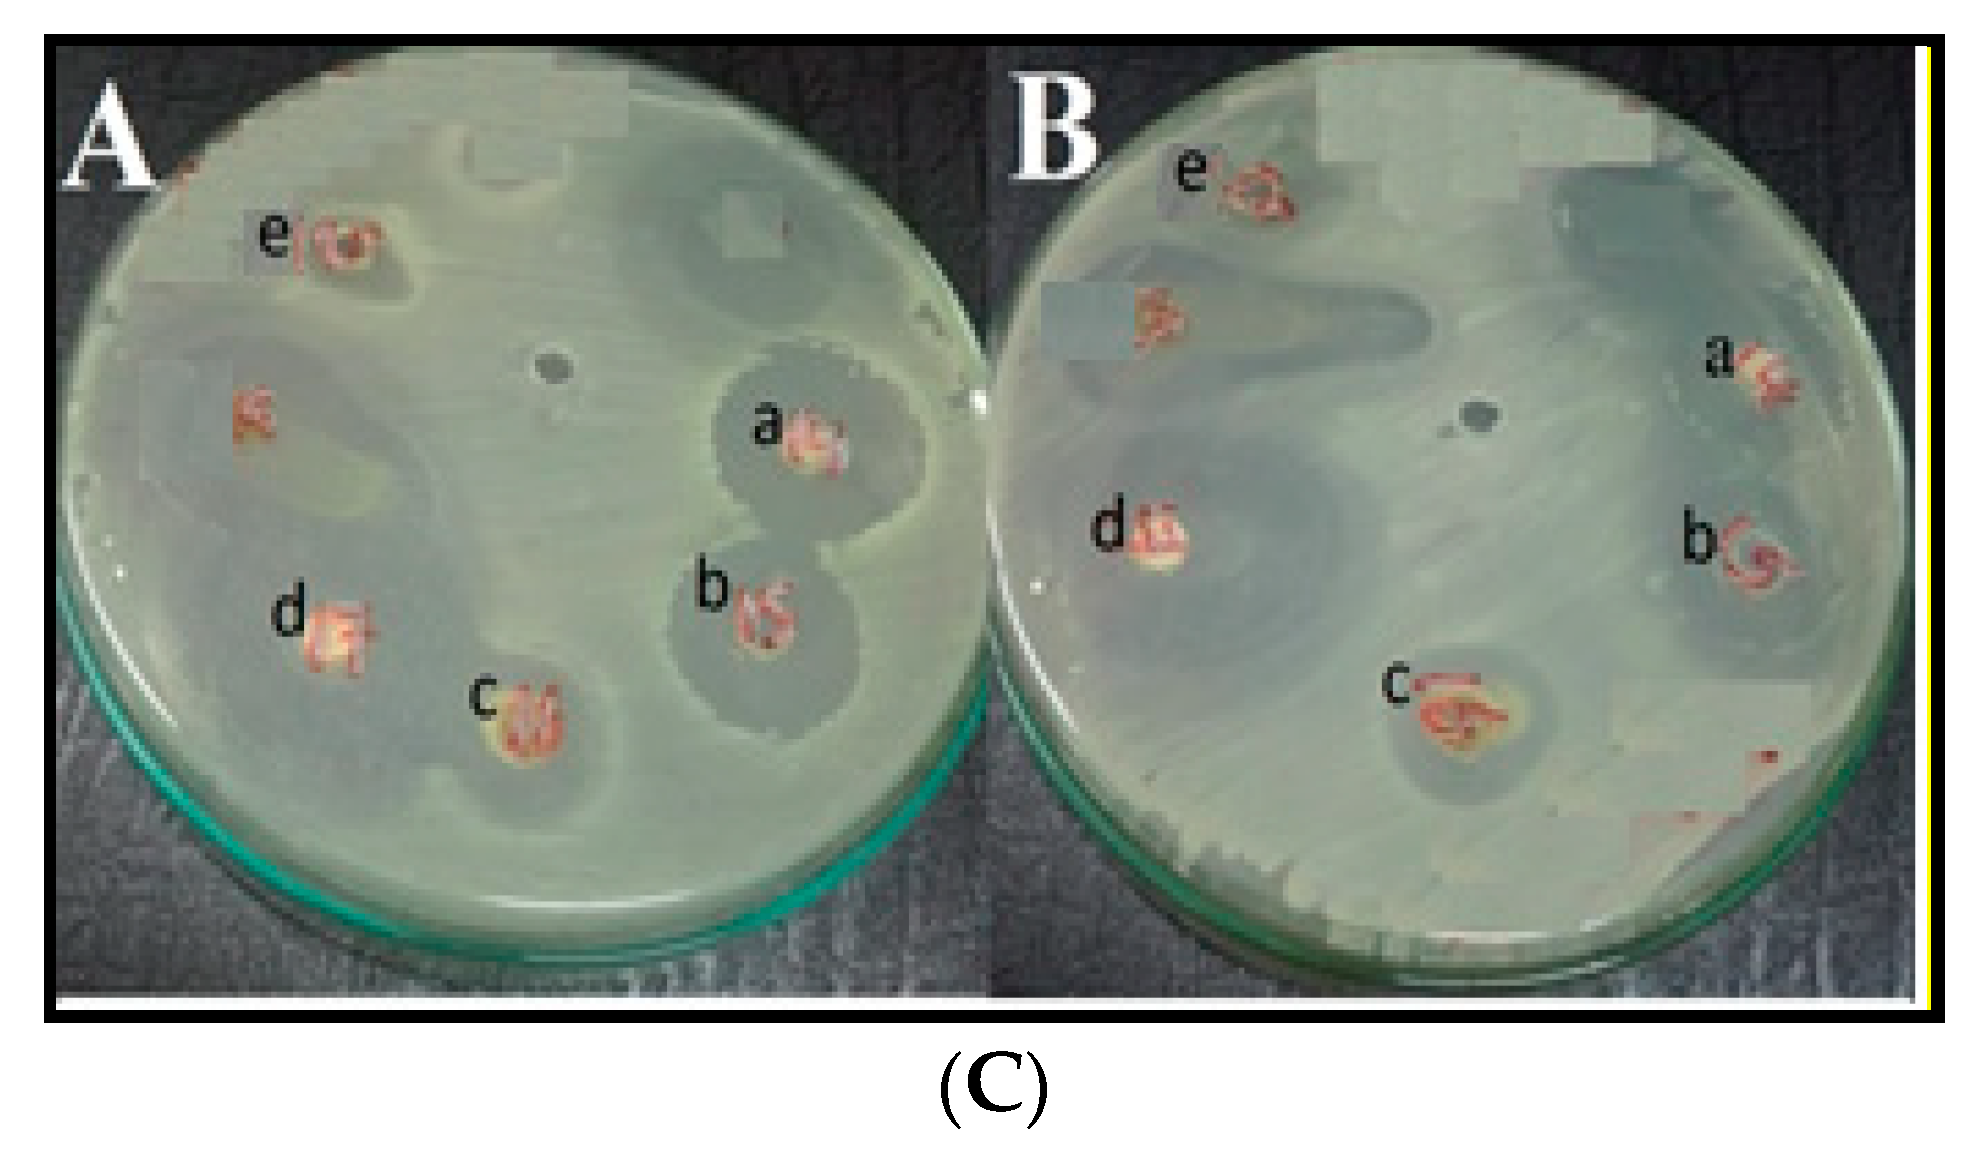
Molecules 26 04725 g010b 550

Synthesis, DFT Calculations, Antiproliferative, Bactericidal Activity and Molecular Docking of Novel Mixed-Ligand Salen/8-Hydroxyquinoline Metal Complexes
Abstract
:1. Introduction
2. Materials and Methods
2.1. Reagents
2.2. Characterization
2.3. Synthesis of Salen
2.4. Synthesis of Mixed Metal Complexes (MSQ)
2.5. Computational Study
2.6. Molecular Docking Study
2.7. PXRD Analysis
2.8. Antimicrobial Potency
2.9. MTT Assay
3. Results and Discussion
3.1. Physicochemical Properties
3.2. 1H NMR and 13C NMR Spectra
3.3. IR Spectra
3.4. Electronic Spectra
3.5. pH Profiles
3.6. ESI-MS Spectra
3.7. PXRD Analysis
3.8. Thermogravimetric Analysis
3.9. DFT Analysis
3.9.1. Molecular DFT Calculation of Salen
3.9.2. [Co(S)(Q)(H2O)]
3.9.3. [Ni(S)(Q)(H2O)]
3.9.4. [Cd(S)(Q)(H2O)]
3.9.5. [Al(S)(Q)(H2O)]+
3.9.6. [La(S)(Q)Cl]H2O
3.10. Antimicrobial Bioassay
3.11. Cytotoxicity
3.12. Molecular Docking Studies
4. Conclusions
- The metal complexes exhibited high cytotoxic potency against human breast cancer (MDA-MB231) and liver cancer (Hep-G2) cell lines.
- The anticancer results showed that the IC50 values of CoSQ and LaSQ were 1.49 and 1.95 µM, respectively, which is comparable to that of cisplatin (1.55 µM) against Hep-G2 cells. On the other hand, CdSQ and LaSQ were the most effective against MDA-MB231, with IC50 values of 1.95 and 1.43 µM, respectively.
- The antibacterial and antifungal efficacies for the MSQ metal complexes decreased in the order AlSQ > LaSQ > CdSQ > gentamycin > NiSQ > CoSQ > Q > S for antibacterial activity, and for antifungal activity followed the trend LaSQ > AlSQ > CdSQ > ketoconazole > NiSQ > CoSQ > Q > S.
- The results of conductivity confirm that the solutions were nonelectrolytes, except that of the Al metal complex, which was found to be ionic.
- The average particle sizes for mixed ligand metal complexes with Cd(II) and La(III) were calculated to be 0.423 and 0.343 nm, respectively.
- On the basis of DFT calculations, we found the geometry of prepared metal complexes to be octahedral.
Supplementary Materials
Author Contributions
Funding
Institutional Review Board Statement
Informed Consent Statement
Data Availability Statement
Acknowledgments
Conflicts of Interest
Sample Availability
References
- Okasha, R.M.; Al-Shaikh, N.E.; Aljohani, F.S.; Naqvi, A.; Ismail, E.H. Design of Novel Oligomeric Mixed Ligand Complexes: Preparation, Biological Applications and the First Example of Their Nanosized Scale. Int. J. Mol. Sci. 2019, 20, 743. [Google Scholar] [CrossRef] [Green Version]
- Qiu, S.; Xue, M.; Zhu, G. Metal–organic framework membranes: From synthesis to separation application. Chem. Soc. Rev. 2014, 43, 6116–6140. [Google Scholar] [CrossRef] [PubMed]
- Phuengphai, P.; Youngme, S.; Gamez, P.; Reedijk, J. Catalytic properties of a series of coordination networks: Cyanosilylation of aldehydes catalyzed by Zn (II)-4, 4′-bpy-carboxylato metal complexes. Dalton Trans. 2010, 39, 7936–7942. [Google Scholar] [CrossRef] [PubMed]
- Bhunia, A.; Dey, S.; Moreno, J.M.; Diaz, U.; Concepcion, P.; Van Hecke, K.; Janiak, C.; Van Der Voort, P. A homochiral vanadium–salen based cadmium bpdc MOF with permanent porosity as an asymmetric catalyst in solvent-free cyanosilylation. Chem. Commun. 2015, 52, 1401–1404. [Google Scholar] [CrossRef]
- Heine, J.; Müller-Buschbaum, K. Engineering metal-based luminescence in coordination polymers and metal–organic frameworks. Chem. Soc. Rev. 2013, 42, 9232–9242. [Google Scholar] [CrossRef] [PubMed]
- Cui, Y.; Yue, Y.; Qian, G.; Chen, B. Luminescent Functional Metal–Organic Frameworks. Chem. Rev. 2011, 112, 1126–1162. [Google Scholar] [CrossRef]
- Hu, Z.; Deibert, B.J.; Li, J. Luminescent metal–organic frameworks for chemical sensing and explosive detection. Chem. Soc. Rev. 2014, 43, 5815–5840. [Google Scholar] [CrossRef] [PubMed] [Green Version]
- Pan, J.; Liu, C.-P.; Jiang, F.-L.; Wu, M.-Y.; Chen, L.; Qian, J.-J.; Su, K.-Z.; Wan, X.-Y.; Hong, M.-C. Diverse architectures and luminescence properties of two novel copper (I) coordination polymers assembled from 2,6-bis [3-(pyrid-4-yl)-1,2,4-triazolyl] pyridine ligands. CrystEngComm 2015, 17, 1541–1548. [Google Scholar] [CrossRef]
- Morris, W.; Volosskiy, B.; Demir, S.; Gándara, F.; McGrier, P.L.; Furukawa, H.; Cascio, D.; Stoddart, J.F.; Yaghi, O.M. Synthesis, structure, and metalation of two new highly porous zirconium metal–organic frameworks. Inorg. Chem. 2012, 51, 6443–6445. [Google Scholar] [CrossRef]
- Burns, C.J.; Field, L.D.; Hambley, T.W.; Lin, T.; Ridley, D.D.; Turner, P.; Wilkinson, M.P. X-Ray crystal structural determination of copper (II)-nitrilotriacetic acid-bis (N-methylimidazol-2-yl) ketone ternary metal complex. ARKIVOC 2001, 7, 157–165. [Google Scholar] [CrossRef] [Green Version]
- Clarke, R.M.; Storr, T. The chemistry and applications of multimetallic salen metal complexes. Dalton Trans. 2014, 43, 9380–9391. [Google Scholar] [CrossRef]
- Atwood, D.A.; Harvey, M.J. Group 13 Compounds Incorporating Salen Ligands. Chem. Rev. 2000, 101, 37–52. [Google Scholar] [CrossRef] [PubMed]
- Karmakar, M.; Chattopadhyay, S. A comprehensive overview of the orientation of tetradentate N2O2 donor Schiff base ligands in octahedral complexes of trivalent 3d metals. J. Mol. Struct. 2019, 1186, 155–186. [Google Scholar] [CrossRef]
- Alvarado-Monzon, J.C.; López, J.A.; de Riquer, G.A.A.; Cristobal, C.; Flores-Alamo, M.; Ruiz-Azuara, L. Iridium (I) homobinuclear metal complexes containing salen-type ligands as bridge. Polyhedron 2019, 161, 243–250. [Google Scholar] [CrossRef]
- Roy, S.; Dey, A.; Drew, M.G.; Ray, P.P.; Chattopadhyay, S. A tetranuclear nickel/lead metal complex with a salen type Schiff base: Synthesis, structure and exploration of photosensitive Schottky barrier diode behaviour. New J. Chem. 2019, 43, 5020–5031. [Google Scholar] [CrossRef]
- Karuppasamy, P.; Thiruppathi, D.; Ganesan, M.; Rajendran, T.; Rajagopal, S.; Sivasubramanian, V.K. Iron (III)–salen ion catalyzed s-oxidation of l-cysteine and s-alkyl-l-cysteines by H2O2: Spectral, kinetic and electrochemical study. Polyhedron 2019, 159, 135–145. [Google Scholar] [CrossRef]
- Pessoa, J.C.; Correia, I. Salan vs. salen metal complexes in catalysis and medicinal applications: Virtues and pitfalls. Coord. Chem. Rev. 2019, 388, 227–247. [Google Scholar] [CrossRef]
- Liang, Y.; Duan, R.-L.; Hu, C.-Y.; Li, L.-L.; Pang, X.; Zhang, W.-X.; Chen, X.-S. Salen-iron complexes: Synthesis, characterization and their reactivity with lactide. Chin. J. Polym. Sci. 2017, 36, 185–189. [Google Scholar] [CrossRef]
- Maru, M.S.; Barroso, S.; Adão, P.; Alves, L.G.; Martins, A.M. New salan and salen vanadium metal complexes: Syntheses and application in sulfoxidation catalysis. J. Organomet. Chem. 2018, 870, 136–144. [Google Scholar] [CrossRef]
- Clarke, R.M.; Herasymchuk, K.; Storr, T. Electronic structure elucidation in oxidized metal–salen metal complexes. Coord. Chem. Rev. 2017, 352, 67–82. [Google Scholar] [CrossRef]
- Vilsinski, B.H.; Murtinho, D.M.; Serra, M.E.; Soares, E.F.; Cruz, P.F.; Braga, G.; Borges, O.; Muniz, E.C.; Rubira, A.F.; Caetano, W. Interactions between copper (II) dibrominated salen metal complex and copolymeric micelles of P-123 and F-127. Colloids Surf. A Physicochem. Eng. Asp. 2017, 532, 583–591. [Google Scholar] [CrossRef]
- Umemura, M.; Kim, J.-H.; Aoyama, H.; Hoshino, Y.; Fukumura, H.; Nakakaji, R.; Sato, I.; Ohtake, M.; Akimoto, T.; Narikawa, M. The iron chelating agent, deferoxamine detoxifies Fe (Salen)-induced cytotoxicity. J. Pharmacol. Sci. 2017, 134, 203–210. [Google Scholar] [CrossRef] [PubMed]
- Thomas, F. Ligand-centred oxidative chemistry in sterically hindered salen metal complexes: An interesting case with nickel. Dalton Trans. 2016, 45, 10866–10877. [Google Scholar] [CrossRef] [PubMed]
- Morales, G.; Delgado, X.; Galeano, L.-A. Effect of the halogen ligand in [Mn(salen)X] metal complexes on the catalytic styrene epoxidation in scCO2. J. CO2 Util. 2015, 12, 82–85. [Google Scholar] [CrossRef]
- Short, B.R.; Vargas, M.A.; Thomas, J.C.; O’Hanlon, S.; Enright, M.C. In vitro activity of a novel compound, the metal ion chelating agent AQ+, against clinical isolates of Staphylococcus aureus. J. Antimicrob. Chemother. 2006, 57, 104–109. [Google Scholar] [CrossRef]
- Vanparia, S.F.; Patel, T.S.; Sojitra, N.A.; Jagani, C.L.; Dixit, B.C.; Patel, P.S.; Dixit, R.B. Synthesis, characterization and antimicrobial study of novel 4-{[(8-hydroxyquinolin-5-yl) methyl] amino} benzenesulfonamide and its oxinates. Acta Chim. Slov. 2010, 57, 600–667. [Google Scholar]
- Enquist, P.-A.; Gylfe, Å.; Hägglund, U.; Lindström, P.; Norberg-Scherman, H.; Sundin, C.; Elofsson, M. Derivatives of 8-hydroxyquinoline—Antibacterial agents that target intra-and extracellular Gram-negative pathogens. Bioorg. Med. Chem. Lett. 2012, 22, 3550–3553. [Google Scholar] [CrossRef]
- Tsumaki, T. Nebenvalenzringverbindungen. IV. Über einige innerkomplexe Kobaltsalze der Oxyaldimine. Bull. Chem. Soc. Jpn. 1938, 13, 252–260. [Google Scholar] [CrossRef] [Green Version]
- Omar, M.; Abd El-Halim, H.F.; Khalil, E.A. Synthesis, characterization, and biological and anticancer studies of mixed ligand metal complexes with Schiff base and 2, 2′-bipyridine. Appl. Organomet. Chem. 2017, 31, e3724. [Google Scholar] [CrossRef]
- Aly, S.A.; Elganzory, H.H.; Mahross, M.H.; Abdalla, E.M. Quantum chemical studies and effect of gamma irradiation on the spectral, thermal, X-ray diffraction and DNA interaction with Pd (II), Cu(I), and Cd (II) of hydrazone derivatives. Appl. Organomet. Chem. 2021, 35, e6153. [Google Scholar] [CrossRef]
- Abu-Dief, A.M.; Abdel-Rahman, L.H.; Abdelhamid, A.A.; Marzouk, A.A.; Shehata, M.R.; Bakheet, M.A.; Almaghrabi, O.A.; Nafady, A. Synthesis and characterization of new Cr(III), Fe(III) and Cu(II) metal complexes incorporating multi-substituted aryl imidazole ligand: Structural, DFT, DNA binding, and biological implications. Spectrochim. Acta A Mol. Biomol. Spectrosc. 2020, 228, 117700. [Google Scholar] [CrossRef] [PubMed]
- Chemical Computing Group Inc. Molecular Operating Environment (MOE); Chemical Computing Group Inc.: Montreal, QC, Canada, 2014. [Google Scholar]
- Abdel-Rahman, L.H.; El-Khatib, R.M.; Nassr, L.A.; Abu-Dief, A.M.; Ismael, M.; Seleem, A.A. Metal based pharmacologically active agents: Synthesis, structural characterization, molecular modeling, CT-DNA binding studies and in vitro antimicrobial screening of iron (II) bromosalicylidene amino acid chelates. Spectrochim. Acta A Mol. Biomol. Spectrosc. 2014, 117, 366–378. [Google Scholar] [CrossRef] [PubMed]
- Darensbourg, D.J.; Ortiz, C.G.; Billodeaux, D.R. Synthesis and structural characterization of iron (III) salen metal complexes possessing appended anionic oxygen donor ligands. Inorg. Chim. Acta 2004, 357, 2143–2149. [Google Scholar] [CrossRef]
- Ansari, K.I.; Grant, J.D.; Woldemariam, G.A.; Kasiri, S.; Mandal, S.S. Iron (III)-salen metal complexes with less DNA cleavage activity exhibit more efficient apoptosis in MCF7 cells. Org. Biomol. Chem. 2009, 7, 926–932. [Google Scholar] [CrossRef] [PubMed]
- Hare, C.R. Visible and Ultra Violet Spectroscopy; John Wiley and Sons: New York, NY, USA, 1968; pp. 112–155. [Google Scholar]
- Abdalla, E.M.; Abdel Rahman, L.H.; Abdelhamid, A.A.; Shehata, M.R.; Alothman, A.A.; Nafady, A. Synthesis, Characterization, Theoretical Studies, and Antimicrobial/Antitumor Potencies of Salen and Salen/Imidazole Metal complexes of Co (II), Ni (II), Cu (II), Cd (II), Al (III) and La (III). Appl. Organomet. Chem. 2020, 34, e5912. [Google Scholar] [CrossRef]
- Kidrič, J.; Hadži, D.; Kocjan, D.; Rutar, V. 1H and13C NMR study of 8-hydroxyquinoline and some of its 5-substituted analogues. Magn. Reson. Chem. 1981, 15, 280–284. [Google Scholar] [CrossRef]
- Baker, B.C.; Sawyer, D.T. Proton nuclear magnetic resonance studies of 8-quinolinol and several of its metal complexes. Anal. Chem. 1968, 40, 1945–1951. [Google Scholar] [CrossRef]
- Mahmoud, W.H.; Deghadi, R.G.; Mohamed, G.G. Preparation, geometric structure, molecular docking thermal and spectroscopic characterization of novel Schiff base ligand and its metal chelates. J. Therm. Anal. Calorim. 2016, 127, 2149–2171. [Google Scholar] [CrossRef]
- Mahmoud, W.H.; Deghadi, R.G.; Mohamed, G.G. Novel Schiff base ligand and its metal metal complexes with some transition elements. Synthesis, spectroscopic, thermal analysis, antimicrobial and in vitro anticancer activity. Appl. Organomet. Chem. 2016, 30, 221–230. [Google Scholar] [CrossRef]
- Abdel-Rahman, L.H.; Abu-Dief, A.M.; Shehata, M.R.; Atlam, F.M.; Abdel-Mawgoud, A.A.H. Some new Ag (I), VO (II) and Pd (II) chelates incorporating tridentate imine ligand: Design, synthesis, structure elucidation, density functional theory calculations for DNA interaction, antimicrobial and anticancer activities and molecular docking studies. Appl. Organomet. Chem. 2019, 33, e4699. [Google Scholar] [CrossRef]
- Ibrahim, E.; Abdel-Rahman, L.H.; Abu-Dief, A.M.; Elshafaie, A.; Hamdan, S.K.; Ahmed, A. The electric and thermoelectric properties of Cu (II)-Schiff base nano-metal complexes. Phys. Scr. 2018, 93, 055801. [Google Scholar] [CrossRef]
- Mishra, N.; Poonia, K.; Soni, S.K.; Kumar, D. Synthesis, characterization and antimicrobial activity of Schiff base Ce (III) metal complexes. Polyhedron 2016, 120, 60–68. [Google Scholar] [CrossRef]
- Ribeiro, N.; Roy, S.; Butenko, N.; Cavaco, I.; Pinheiro, T.; Alho, I.; Marques, F.; Avecilla, F.; Pessoa, J.C.; Correia, I. New Cu (II) metal complexes with pyrazolyl derived Schiff base ligands: Synthesis and biological evaluation. J. Inorg. Biochem. 2017, 174, 63–75. [Google Scholar] [CrossRef] [PubMed]
- Liu, Y.-T.; Lian, G.-D.; Yin, D.-W.; Su, B.-J. Synthesis, characterization and biological activity of ferrocene-based Schiff base ligands and their metal (II) complexes. Spectrochim. Acta Part A Mol. Biomol. Spectrosc. 2013, 100, 131–137. [Google Scholar] [CrossRef] [PubMed]
- Marzilli, L.G. Bioinorganic Catalysis; Reedijk J & Marcel Dekker: New York, NY, USA, 1993. [Google Scholar]
- Anjaneyulu, Y.; Rao, R.P. Preparation, characterization and antimicrobial activity studies on some ternary metal complexes of Cu (II) with acetylacetone and various salicylic acids. Synth. React. Inorg. Met. Org. Chem. 1986, 16, 257–272. [Google Scholar] [CrossRef]
- Santos, A.F.; Brotto, D.F.; Favarin, L.R.; Cabeza, N.A.; Andrade, G.R.; Batistote, M.; Cavalheiro, A.A.; Neves, A.; Rodrigues, D.C.; Dos Anjos, A. Study of the antimicrobial activity of metal complexes and their ligands through bioassays applied to plant extracts. Rev. Bras. Farm. 2014, 24, 309–315. [Google Scholar] [CrossRef] [Green Version]
- Bisceglie, F.; Bacci, C.; Vismarra, A.; Barilli, E.; Pioli, M.; Orsoni, N.; Pelosi, G. Antibacterial activity of metal complexes based on cinnamaldehyde thiosemicarbazone analogues. J. Inorg. Biochem. 2020, 203, 110888. [Google Scholar] [CrossRef] [PubMed]
- Dharmaraj, N.; Viswanathamurthi, P.; Natarajan, K. Ruthenium (II) metal complexes containing bidentate Schiff bases and their antifungal activity. Trans. Met. Chem. 2001, 26, 105–109. [Google Scholar] [CrossRef]
- Joseyphus, R.S.; Nair, M.S. Antibacterial and antifungal studies on some schiff base metal complexes of zinc (II). Mycobiology 2008, 36, 93–98. [Google Scholar] [CrossRef] [PubMed] [Green Version]
- Abyar, S.; Khandar, A.A.; Salehi, R.; Hosseini-Yazdi, S.A.; Alizadeh, E.; Mahkam, M.; Jamalpoor, A.; White, J.M.; Shojaei, M.; Aizpurua-Olaizola, O. In vitro nephrotoxicity and anticancer potency of newly synthesized cadmium metal complexes. Sci. Rep. 2019, 9, 1–11. [Google Scholar] [CrossRef] [Green Version]
- Zhou, X.; Koizumi, Y.; Zhang, M.; Natsui, M.; Koyota, S.; Yamada, M.; Kondo, Y.; Hamada, F.; Sugiyama, T. Cadmium-coordinated supramolecule suppresses tumor growth of T-cell leukemia in mice. Cancer Sci. 2015, 106, 635–641. [Google Scholar] [CrossRef] [PubMed]
- Karmakar, T.; Kuang, Y.; Neamati, N.; Baruah, J.B. Cadmium metal complexes and cocrystals of indium metal complexes of benzothiazole derivatives and anticancer activities of the cadmium metal complexes. Polyhedron 2013, 54, 285–293. [Google Scholar] [CrossRef]

| Compounds Molecular Formula | Molecular Weight | Color Yield % | Conductivity µs | M. P. °C | µeff BM | Found (cal.) % | |||
|---|---|---|---|---|---|---|---|---|---|
| C | H | N | M | ||||||
| Salen | 268.31 | Yellow | 0.83 | 127 | 0.576 | 71.32 (71.62) | 5.95 (6.01) | 10.28 (10.44) | - |
| C16H16N2O2 | 95 | ||||||||
| 8-Hydroxyquinoline | 145.16 | White | - | 76 | - | 74.25 (74.47) | 4.67 (4.86) | 9.49 (9.65) | - |
| C9H7NO | - | ||||||||
| Co(S)(Q)H2O | 488.4 | Dark brown | 42.8 | 260 | 2.3 | 61.34 (61.48) | 4.51 (4.75) | 8.52 (8.60) | 11.99 (12.07) |
| C25H23CoN3O4 | 89 | ||||||||
| Ni(S)(Q)H2O | 497.16 | Brownish red | 53.3 | >300 | 1.4 | 60.21 (60.34) | 4.59 (4.82) | 8.12 (8.44) | 11.69 (11.80) |
| [C25H23N3NiO4]0.5H2O | 75 | ||||||||
| Cd(S)(Q)H2O | 541.88 | Dark yellow | 34.8 | 282 | Dia. | 55.15 (55.41) | 4.08 (4.28) | 7.52 (7.75) | 20.61 (20.74) |
| C25H23CdN3O4 | 79 | ||||||||
| Al(S)(Q)H2O | 491.95 | Light yellow | 103.5 | 265 | Dia. | 60.81 (61.04) | 4.53 (4.71) | 8.39 (8.54) | 5.23 (5.49) |
| [C25H23AlN3O4]+Cl− | 74 | ||||||||
| La(S)(Q)H2O | 603.83 | Dark yellow | 39.8 | 260 | Dia. | 49.31 (49.73) | 3.62 (3.84) | 6.74 (6.96) | 22.91 (23.00) |
| [C25H21ClLaN3O3]H2O | 78 | ||||||||
| Metal Complex | 1H NMR(DMSO-d6/D2O, 400 MHz) | 13C NMR(100 MHz, DMSO-d6) |
|---|---|---|
| CdSQ | 2.51–2.81 (t., 4H, Ph-CH=N- CH2-CH2-N), 3.17 (br. s., 2H, H2O for complex), 3.80-3.93 (br. S., 2H, 2OH (OH for hydroxyquinoline+ OH for phenolic ring)), 6.90–7.47 (m., 10H, (phenyl + quinoline)), 7.49–8.71 (m., 6H, 4H cyclic+ 1H olefin+ 1H for NH) | 59.21, 112.39, 113.35, 121.80, 129.22, 129.96, 138.10, 139.66, 146.93, 158.98 |
| AlSQ | 3.30 (br. s., 2H, H2O for complex), 3.83–4.05 (t., 4H, Ph-CH=N-CH2-CH2-N), 6.66-7.36 (m., 10H, (phenyl + quinoline)), 7.49–8.62 (m., 6H, 4H cyclic+ 2H olefin), 13.34 (br. s., 1H for NH) | 53.53, 56.47, 111.88, 116.38, 120.04, 121.65, 134.58, 135.50, 164.96, 167.57 |
| Compound | ν(OH) | ν(NH) | ν(CH)arom | ν(CH)aliph | ν(C=O) | ν(C=N) | ν(C–O) | ν(H2O)Coordinated | ν(M–O) | ν(M–N) |
|---|---|---|---|---|---|---|---|---|---|---|
| Salen | 3292 | - | 3049–3007 | 2899–2867 | - | 1608 | 1247 | - | - | - |
| CoSQ | 3731 | 3173 | 3017 | 2970 | 1740 | 1637 | 1226 | 950 | 527 | 445 |
| NiSQ | 3432 | 3229 | 3049 | 2968–2796 | 1740 | 1626 | 1213 | 903 | 538 | 441 |
| CdSQ | 3461 | 3137 | 3031 | 2947 | 1740 | 1633 | 1214 | 976 | 578 | 494 |
| AlSQ | 3349 | 3191 | 3008 | 2972–2867 | 1740 | 1634 | 1207 | 980 | 545 | 485 |
| LaSQ | 3449 | 3142 | 3051 | 2997–2798 | 1739 | 1621 | 1230 | - | 533 | 484 |
| Compounds | Crystallographic Parameters | ||||
|---|---|---|---|---|---|
| Crystal System | D (nm) | a (nm) | b (nm) | c (nm) | |
| CdS | Monoclinic | 49.93 | 6.98 | 14.90 | 10.41 |
| CdSQ | Triclinic | 38.55 | 9.01 | 11.16 | 13.24 |
| LaS | Monoclinic | 77.08 | 7.56 | 25.72 | 8.17 |
| LaSQ | Monoclinic | 62.23 | 10.39 | 10.22 | 8.70 |
| Salen | Monoclinic | 95.98 | 9.80 | 8.78 | 17.24 |
| Compounds | Temp. Range °C | Weight Lost.% calc (Found) | Assignments |
|---|---|---|---|
| CoSQ | 100–250 | 3.65 (3.68) 5.70 (5.73) 13.15 (13.10) 31.90 (31.94) 10.60 (10.64) 22.50 (22.73) | H2O |
| C25H23CoN3O4 | 250–290 | C2H4 | |
| 290–395 | C4H2N | ||
| 395–490 | C10H6NO | ||
| 490–580 | C4H4 | ||
| 580–740 | C5H5NO2 | ||
| Residue | >740 | Co | |
| NiSQ | 25–260 | 3.70 (5.43) 41.85 (41.80) 26.61 (26.63) 15.65 (15.77) | 3/2 H2O |
| [C25H23N3NiO4]0.5H2O | 260–320 | C11H12N2O2 | |
| 320–400 | C8H4NO | ||
| 400–620 | C6H5 | ||
| Residue | >620 | Ni | |
| CdSQ | 35–200 | 3.30 (3.32) 21.38 (21.44) 6.10 (5.54) 48.47 (48.90) | H2O |
| C25H23CdN3O4 | 200–340 | C5H10NO2 | |
| 340–465 | CH2O | ||
| 465–655 | C19H9N2 | ||
| Residue | >665 | Cd | |
| AlSQ | 90–200 | 19.9 (20.42) 14.20 (14.34) 25.85 (26.01) 10.55 (10.57) 22.72 (22.69) | H2O, HCl, NO2 |
| [C25H23AlN3O4]+Cl− | 200–325 | C3H5NO | |
| 325–400 | C9H6N | ||
| 400–490 | C4H4 | ||
| 490–710 | C9H5 | ||
| Residue | >710 | Al | |
| LaSQ | 35–200 | 3.32 (2.98) 21.31 (21.28) 8.81 (8.61) 7.40 (7.28) 5.10 (4.97) 30.96 (31.79) | H2O |
| [C25H21ClLaN3O3]H2O | 200–265 | C5H3NOCl | |
| 265–320 | C4H4 | ||
| 320–360 | N2O | ||
| 360–385 | CH2O | ||
| 385–625 | C15H12 | ||
| Residue | >625 | La |
| Bond | Length (Å) | Bond | Angle (°) | Bond | Length (Å) | Bond | Angle (°) |
| Metal Complex 1 CoSQ | Metal Complex 2 NiSQ | ||||||
| Co–N1 | 1.908 | N1–Co–N2 | 80.28 | Ni–N1 | 2.151 | N1–Ni–N2 | 78.22 |
| Co–N2 | 2.272 | N3–Co–O4 | 82.38 | Ni–N2 | 2.249 | N3–Ni–O4 | 78.98 |
| Co–N3 | 1.993 | N1–Co–O4 | 91.04 | Ni–N3 | 2.288 | N1–Ni–O4 | 100.1 |
| Co–O4 | 2.113 | N2–Co–N3 | 106.6 | Ni–O4 | 2.071 | N2–Ni–N3 | 102.8 |
| Co–O2 | 2.007 | O2–Co–N1 | 88.00 | Ni–O2 | 1.860 | O2–Ni–N1 | 84.96 |
| Co–O3 | 2.162 | O2–Co–N2 | 90.52 | Ni–O3 | 1.997 | O2–Ni–N2 | 91.27 |
| O2–Co–N3 | 89.90 | O2–Ni–N3 | 93.69 | ||||
| O2–Co–O4 | 96.57 | O2–Ni–O4 | 92.46 | ||||
| Bond | Length (Å) | Bond | Angle (°) | ||||
| Metal Complex 3 CdSQ | |||||||
| Cd–N1 | 2.227 | N1–Cd–N2 | 76.87 | ||||
| Cd–N2 | 2.409 | N3–Cd–O4 | 77.40 | ||||
| Cd–N3 | 2.312 | N1–Cd–O4 | 99.93 | ||||
| Cd–O4 | 2.219 | N2–Cd–N3 | 106.2 | ||||
| Cd–O2 | 2.231 | O2–Cd–N1 | 80.28 | ||||
| Cd–O3 | 2.372 | O2–Cd–N2 | 92.34 | ||||
| O2–Cd–N3 | 95.24 | ||||||
| O2–Cd–O4 | 92.80 | ||||||
| Bond | Length (Å) | Bond | Angle (°) | Bond | Length (Å) | Bond | Angle (°) |
| Metal Complex 4 AlSQ | Metal Complex 5 LaSQ | ||||||
| Al–N1 | 1.974 | N1–Al–N2 | 81.42 | La–N1 | 2.534 | N1–La–N2 | 69.55 |
| Al–N2 | 2.122 | N3–Al–O4 | 83.86 | La–N2 | 2.704 | N3–La–O3 | 69.70 |
| Al–N3 | 2.065 | N1–Al–O4 | 95.59 | La–O3 | 2.402 | N1–La–O3 | 107.2 |
| Al–O4 | 1.891 | N2–Al–N3 | −104.9 | La–N3 | 2.621 | N2–La–N3 | 113.5 |
| Al–O2 | 1.869 | O2–Al–N1 | 88.13 | La–Cl | 2.828 | O2–La–N1 | 75.55 |
| Al–O3 | 2.052 | O2–Al–N2 | 92.34 | La–O2 | 2.396 | O2–La–N2 | 91.96 |
| O2–Al–N3 | 91.84 | O2–La–N3 | 97.13 | ||||
| O2–Al–O4 | 97.74 | O2–La–O3 | 87.36 |
| Compounds | E a | HOMO b | LUMO c | Eg d | Dipole Moment e |
|---|---|---|---|---|---|
| L (Keto-Enol) | −879.513 | −5.6271 | −2.0787 | 3.5484 | 4.3162 |
| [Co(S)(Q)(H2O)] | −1576.606 | −4.7207 | −2.8774 | 1.8433 | 4.0495 |
| [Ni(S)(Q)(H2O)] | −1600.769 | −4.5141 | −2.8635 | 1.6506 | 4.6864 |
| [Cd(S)(Q)(H2O)] | −1479.550 | −4.7561 | −3.1797 | 1.5764 | 6.0024 |
| [Al(S)(Q)H2O]+ | −1433.425 | −8.3346 | −6.0168 | 2.3178 | 3.9957 |
| [La(S)(Q)Cl]H2O | −1401.433 | −5.1707 | −3.7108 | 1.4599 | 11.4398 |
| Compounds | IC50 Values µM | ||
|---|---|---|---|
| Hep-G2 Cell Line | MDA-MB231 Cell Line | HEK-293 Cell Lines | |
| Cisplatin | 1.55 ± 0.06 | 1.87 ± 0.09 | 94.10 ± 0.05 |
| S | 1.10 ± 0.10 | 27.54 ± 0.08 | 93.06 ± 0.04 |
| CoSQ | 1.49 ± 0.09 | 109.64 ± 0.11 | 91.80 ± 0.07 |
| NiSQ | 67.6 ± 0.04 | 102.32 ± 0.07 | 93.05 ± 0.05 |
| CdSQ | 6.19 ± 0.08 | 1.95 ± 0.10 | 91.88 ± 0.08 |
| AlSQ | 5.72 ± 0.13 | 2.66 ± 0.05 | 91.90 ± 0.05 |
| LaSQ | 1.95 ± 0.06 | 1.43 ± 0.12 | 93.03 ± 0.10 |
| Compounds | Receptor | Interaction | Distance (Å) * | E (Kcal/mol) |
|---|---|---|---|---|
| Ligand | ||||
| O 16 | O ASN 90 | H-donor | 3.03 (2.06) | −3.1 |
| Cd(II) metal complex | ||||
| N 18 | OE1 GLU 100 | H-donor | 3.04 (2.02) | −13.3 |
| N 17 | OE1 GLU 100 | Ionic | 3.68 | −1.3 |
| N 17 | OE2 GLU 100 | Ionic | 3.85 | −0.8 |
| N 18 | OE1 GLU 100 | Ionic | 3.04 | −4.2 |
| N 18 | OE2 GLU 100 | Ionic | 3.48 | −2.0 |
| N 44 | OD1 ASP 208 | Ionic | 3.41 | −2.3 |
Publisher’s Note: MDPI stays neutral with regard to jurisdictional claims in published maps and institutional affiliations. |
© 2021 by the authors. Licensee MDPI, Basel, Switzerland. This article is an open access article distributed under the terms and conditions of the Creative Commons Attribution (CC BY) license (https://creativecommons.org/licenses/by/4.0/).
Share and Cite
Al-Farhan, B.S.; Basha, M.T.; Abdel Rahman, L.H.; El-Saghier, A.M.M.; Abou El-Ezz, D.; Marzouk, A.A.; Shehata, M.R.; Abdalla, E.M. Synthesis, DFT Calculations, Antiproliferative, Bactericidal Activity and Molecular Docking of Novel Mixed-Ligand Salen/8-Hydroxyquinoline Metal Complexes. Molecules 2021, 26, 4725. https://doi.org/10.3390/molecules26164725
Al-Farhan BS, Basha MT, Abdel Rahman LH, El-Saghier AMM, Abou El-Ezz D, Marzouk AA, Shehata MR, Abdalla EM. Synthesis, DFT Calculations, Antiproliferative, Bactericidal Activity and Molecular Docking of Novel Mixed-Ligand Salen/8-Hydroxyquinoline Metal Complexes. Molecules. 2021; 26(16):4725. https://doi.org/10.3390/molecules26164725
Chicago/Turabian StyleAl-Farhan, Badriah Saad, Maram T. Basha, Laila H. Abdel Rahman, Ahmed M. M. El-Saghier, Doaa Abou El-Ezz, Adel A. Marzouk, Mohamed R. Shehata, and Ehab M. Abdalla. 2021. "Synthesis, DFT Calculations, Antiproliferative, Bactericidal Activity and Molecular Docking of Novel Mixed-Ligand Salen/8-Hydroxyquinoline Metal Complexes" Molecules 26, no. 16: 4725. https://doi.org/10.3390/molecules26164725
APA StyleAl-Farhan, B. S., Basha, M. T., Abdel Rahman, L. H., El-Saghier, A. M. M., Abou El-Ezz, D., Marzouk, A. A., Shehata, M. R., & Abdalla, E. M. (2021). Synthesis, DFT Calculations, Antiproliferative, Bactericidal Activity and Molecular Docking of Novel Mixed-Ligand Salen/8-Hydroxyquinoline Metal Complexes. Molecules, 26(16), 4725. https://doi.org/10.3390/molecules26164725

